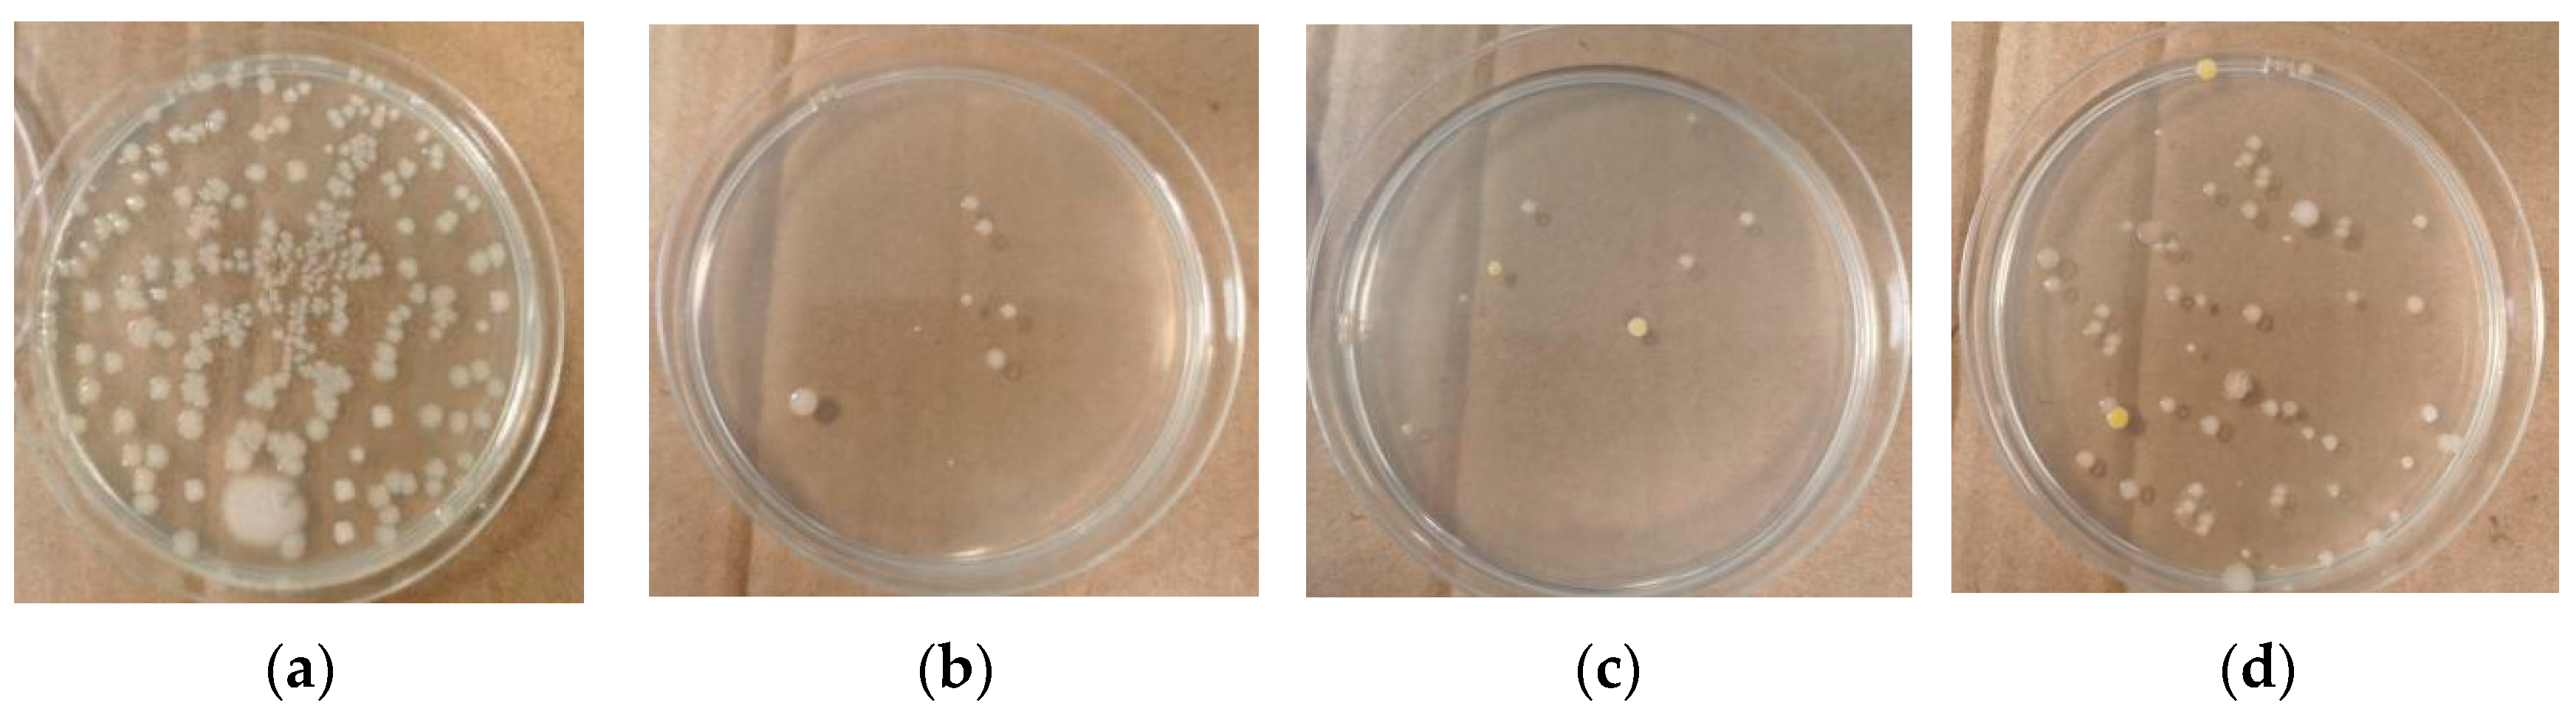
Agriculture 14 00509 g013

1. Introduction
Liquid egg is a significant research focus in the deep processing of eggs and the food industry [
1]. Moreover, the utilization of raw materials in liquid eggs in the food industry can be applied to the production of various foods, such as pastries, meat products, and dairy products. In the baking industry, the utilization of egg whites and egg yolks in whole egg liquid contributes to the formation of food structure. In particular, the foaming properties of whole egg liquid serve as a leavening agent in the food industry, enhancing and maintaining the quality of aerated foods, such as cakes and cookies [
2]. Liquid egg mainly includes liquid whole egg, liquid egg white, liquid egg yolk, and special egg solutions with added salt or sugar. Compared to shell eggs, liquid egg products can retain all the nutritional characteristics of eggs and effectively address issues such as the fragility, transportation, and storage difficulties of fresh shell eggs [
3,
4]. Liquid egg processing involves removing natural defense barriers such as the eggshell and membrane, making it susceptible to microbial growth during various production processes [
5], hence the necessity for sterilization to ensure safety. On this basis, further improving the functionality and nutritional characteristics of liquid egg products is also a research focus [
6].
Liquid egg products are highly heat-sensitive, with protein coagulation temperatures of 62–64 °C for egg whites and 68–71.15 °C for egg yolks [
7]. The critical challenge in liquid egg production is how to ensure sterilization intensity without compromising the functional properties and nutritional value of liquid egg products. In the United States, Japan, Europe, and Australia, the predominant intervention to enhance the microbial safety of liquid eggs in the egg industry is pasteurization [
8]. Pasteurization processing of liquid eggs accounts for 30–40% of egg production [
9]. Due to the difficulty of controlling the temperature of pasteurization, ensuring the efficiency of sterilization becomes challenging. If the pasteurization temperature is too low, insufficient sterilization may lead to product spoilage, while excessively high temperatures can adversely affect the functional and sensory properties of eggs. Moreover, different countries have slightly varied requirements for pasteurization temperature and time [
10]. In order to minimize the adverse effects of pasteurization on liquid eggs, various new processing techniques have been extensively explored. For example, Geveke et al. [
11] utilized radiofrequency (RF) heating and pasteurization to process liquid whole eggs, resulting in a reduction of over 6 logarithmic units in the quantity of Escherichia coli and a similar decrease in the count of Escherichia coli. Studies by Yan et al. [
12] found that super-high pressure sterilization conditions at 300–450 MPa for 15 min were necessary to reduce pathogenic bacteria, such as Listeria monocytogenes and Salmonella, in egg products to 2 logarithmic units. However, pressures exceeding 300 Mpa led to increased protein viscosity, denaturation, and aggregation. Hermawan et al. [
13] demonstrated the sterilization effectiveness of pulsed electric field (PEF) technology on Salmonella in liquid whole eggs. Yuk and Geveke [
14] found that the extent of sublethal injury in surviving Lactobacillus plantarum cells increased with the rise in CO2 concentration and processing temperature. Under high-pressure CO
2 sterilization conditions of 5 Mpa, 25 °C, for 20–30 min, the sublethal proportion of Escherichia coli sharply increased to 72.4%. Furthermore, with an extension of processing time to 60 min, the sublethal proportion of Escherichia coli significantly rose to 100%. Some researchers have also found that, for most pathogenic bacteria, combination therapy may be more effective than individual treatment. Compared to traditional pasteurization methods, these novel processing techniques excel in eliminating foodborne pathogens and maintaining the nutrition and quality of liquid eggs.
Ultrasonic technology, as a typical non-thermal sterilization method, can inactivate microorganisms through mechanisms such as cavitation, local heating, and mechanical vibration. It has been widely applied for sterilizing heat-sensitive foods such as milk and beverages [
15]. Scholars such as Cao et al. [
16] conducted ultrasonic sterilization treatment on barley grass, demonstrating that ultrasonic sterilization treatment can effectively enhance the its microbial safety, sensory quality, and storage stability. Research has found that the individual sterilization effect of ultrasound is limited, especially against spores and fungi with strong resistance, resulting in a moderate sterilization effect and significant impact on food quality. The U.S. Food and Drug Administration also does not recommend using single ultrasound as the sterilization process in food production [
17]. However, ultrasound in combination with other sterilization methods can effectively reduce processing time, enhance sterilization effectiveness, and, at the same time, maximally preserve the active ingredients in food. For instance, researchers such as Manas [
18] studied the synergy of 20 kHz ultrasound with high pressure. With a constant ultrasound frequency and an increase in pressure from 0 to 200 kPa, the D-value (time required for a 90% reduction in bacterial population) in the test buffer decreased from 5.7 min to 2.5 min. Huang et al. [
19] studied the effects of pulsed electric field, hydraulic high pressure, and ultrasonic treatment alone, and in combination, on the inactivation of Salmonella in liquid eggs. However, due to cost and efficiency considerations, these methods have not been widely adopted on a large scale. Scholars such as Li et al. [
20] investigated the simultaneous damage to membranes and the inhibition of esterase during ultrasonic treatment, resulting in a direct lethal effect. Bacteria under 55 °C heating conditions were inactivated through lethal damage. Scholars such as Lee et al. [
21], through the development of an ultrasonic sterilization device, discovered that the use of single-frequency ultrasonication combined with heat can effectively sterilize while preserving the sensory qualities of food. Therefore, the combination of low-frequency, high-intensity ultrasonic waves with mild heat in a synergistic manner, forming a dual-barrier factor, can reduce the requirements on ultrasonic equipment and heat treatment intensity. This not only ensures the functional properties of liquid eggs but also further enhances sterilization efficiency. Li et al. [
22] combined the application of ultrasound and microwaves in food processing, where microwaves accelerate heating rates, and ultrasound improves the efficiency of heat and mass transfer. The synergy of the heating effect of microwaves and the cavitation effect of ultrasound enhances processing efficiency and disrupts the cellular structure of materials. Therefore, the above studies indicate that the synergistic use of ultrasound with other sterilization methods yields better results than individual sterilization.
This paper focuses on the design and implementation of a sterilization system using ultrasound as the primary means, supplemented by thermal effects. A Modbus-based ultrasound–thermal synergistic sterilization system is constructed. The simulation of ultrasound field distribution is conducted using COMSOL. Single-factor and multi-factor experiments are designed for ultrasound frequency, temperature, and processing time for liquid egg sterilization. A response surface is employed to explore the comprehensive impact of process parameters on liquid egg sterilization efficiency and foaming properties. The NSGA2 genetic algorithm is used to obtain optimal process parameters, and sterilization experiments are conducted for validation.
2. Materials and Methods
2.1. The Ultrasonic–Thermal Synergistic Sterilization System Proposal
The ultrasonic–thermal synergistic hardware system comprises an ultrasonic system and a constant temperature water bath system. Two ultrasonic generators supporting RS485 communication are connected to four ultrasonic transducers, forming a multifrequency ultrasonic system. The constant temperature water bath system consists of a temperature controller, a heater, and an AC contactor. Coordinated control of the ultrasonic–thermal dual system is carried out in the upper computer software based on the Modbus-RTU communication protocol. The ultrasonic generator and temperature controller are directly powered by a 220 V power supply, while the heating rod and temperature sensor are powered and operated through a low-voltage power supply. A USB/RS485 converter connects the ultrasonic–thermal synergistic control system to the upper computer for data transmission. The general experimental process is as follows: firstly, prepare liquid whole egg. After processing with the ultrasonic–thermal synergistic sterilization system, conduct sterilization rate and functional property testing on the treated egg liquid. Finally, the experimental results indicate that the ultrasonic–thermal synergistic sterilization system exhibits good sterilization effectiveness for liquid eggs. The overall scheme of the ultrasonic–thermal synergistic liquid egg sterilization system is shown in
Figure 1.
2.2. Design of Ultrasonic Sterilization System Device
The ultrasonic generator system consists of two ultrasonic generators, each connected to two sets of ultrasonic transducers. One generator is a 20 kHz single-frequency, controlling two transducers with frequencies both set at 20 kHz. The other generator is a switchable dual-frequency generator with 28 kHz and 40 kHz, connected to two dual-frequency transducers with frequencies of 28 kHz and 40 kHz, respectively. The driving power of the 20 kHz ultrasonic generator is 600 W, with a maximum current of 5 A. The driving power of the 28/40 kHz ultrasonic generator is 300 W, with a maximum current of 4.5 A.
The ultrasonic generator mainly consists of a rectification and filtering circuit, a BUCK chopping circuit, a high-frequency inverter circuit, and a transformer. Its operation process is as follows: when connected to 220 V AC power, the rectification and filtering circuit first convert the AC voltage into 315 V DC voltage. Subsequently, to adjust the output power, the DC chopping circuit outputs DC voltage. To obtain smooth DC, a low-pass filter is used to adjust the BUCK chopping circuit. Simultaneously, a large capacitor filtering capacitor is used to obtain low-ripple DC. Adjust the DC current to the desired voltage, and, finally, through the high-frequency inverter circuit and transformer, convert the DC current into the high-frequency electrical signal required by the ultrasonic transducer, thereby causing the ultrasonic transducer to vibrate and operate. The framework diagram and physical diagram of the ultrasonic generator system are shown in
Figure 2 and
Figure 3, respectively.
2.3. Design of Constant Temperature Water Bath System
The constant temperature water bath provides a stable heat source for the heating of liquid eggs and serves as an additional sterilization effect based on temperature. The temperature control part of the constant temperature heating device uses a temperature sensor inside the water bath for temperature feedback control. The heating part of the device connects the low-voltage output of the constant temperature controller to the AC contactor to control the starting and stopping of the 24 V power supply, indirectly controlling the operation of the heater to ensure temperature stability. Different temperatures can be set to synergize with the ultrasonic generator for sterilization experiments.
The constant temperature water bath system ©s primarily controlled by the constant temperature controller. The upper computer can set different temperatures and action times based on the ultrasonic frequency, thus working together for synergistic sterilization. The main hardware includes a constant temperature controller supporting RS485 communication, a 24 V power supply, an AC contactor, a heater, and a temperature sensor. The overall hardware structure diagram of the constant temperature water bath system is shown in
Figure 4.
2.4. Control Software Design
The ultrasonic–thermal synergistic sterilization control system adopts the form of “PC + Modbus-RTU communication protocol”. Through software developed on the PC, it communicates via the RS485 bus with devices such as ultrasonic generators, temperature sensors, and constant temperature controllers in the lower machine that have Modbus communication protocol. It sends read and write commands to the microcontroller registers and coils of each device, controlling the collaborative work of devices and data collection.
The functions of the ultrasonic–thermal synergistic control software are mainly managed by three modules: (1) function selection nodule, (2) ultrasonic water bath synergistic control module, and (3) intelligent processing module. The upper computer software communicates via the ModbusRTU protocol with the ultrasonic generator and the constant temperature controller, and, after receiving signals in the microcontroller registers, the temperature controller heats the water bath to the specified temperature. Simultaneously, it changes the start–stop status and frequency of the two ultrasonic generators to achieve the effects of multiple frequencies in synergy with water bath constant temperature heating for sterilization. After reaching the designated time point, the ultrasonic generator and constant temperature controller will stop working. The PC simultaneously reads data, such as the actual working frequency of the ultrasonic transducer, the sterilization temperature, and other status information, and saves it.
2.5. Simulation of Ultrasonic–Thermal Synergistic Action Based on COMSOL
In order to achieve multiphysics simulation of multi-frequency ultrasonic transducers and guide the design of transducer layout, simulations of both a single ultrasonic transducer and a multi-frequency ultrasonic transducer were conducted using the “Acoustic–Piezoelectric Interaction, Time Domain” analysis module in the COMSOL 6.0 software.
2.5.1. Parameter Settings
The effective range covered by the ultrasonic transducer is approximately 100 mm along the acoustic axis, with coverage on both sides of the acoustic axis being approximately 50 mm each. The sterilization container can be designed as a rectangular container with dimensions of 200 mm × 100 mm × 100 mm to ensure that the ultrasonic waves cover the entire container. The simulated ultrasonic frequency is 28 kHz, and the mesh size in the liquid domain is set between 2.68 mm and 5.36 mm. The meshing of the ultrasonic transducer section is chosen to be automatically partitioned by the system, as shown in
Figure 5. The main simulation parameters are presented in
Table 1.
Multi-frequency transducers with frequencies of 20 kHz and 40 kHz are arranged with four ultrasonic transducers distributed along the two long sides of the container. The center distance between transducers is 100 mm. In the boundary settings, the middle surface of the piezoelectric ceramic of the four ultrasonic transducers is set as the positive pole, while the other eight surfaces are set as the negative pole. The ultrasonic frequencies at the voltage boundaries of the piezoelectric material are set to 20 kHz and 40 kHz, with voltages being sinusoidal wave excitations measured in practice. According to the multi-frequency ultrasonic frequencies, the mesh size is divided into one-fifth to one-tenth of the wavelength. The meshing is shown in
Figure 6, and the main simulation parameters are set as shown in
Table 2.
2.5.2. Simulation Results
The simulated sound pressure and propagation attenuation curve of a single ultrasonic transducer under excitation are shown in
Figure 7a,b. The wave-radiating sound field of a single ultrasonic transducer exhibits clear directionality, with energy concentrated mainly near the center axis of the transducer. The amplitude of the sound pressure along the acoustic axis shows a rapid exponential decay, attenuating to around Pa at a distance of z = 100 mm from the sound source, and gradually leveling off thereafter. Therefore, the effective range covered by a single ultrasonic transducer can be approximately 100 mm along the acoustic axis, with coverage on both sides of the acoustic axis being approximately 50 mm.
The distribution of the sound field and the sound pressure curve of the multi-frequency ultrasonic array are shown in
Figure 8a,b. The arrangement of transducers in the multi-frequency ultrasonic array can increase the acoustic intensity in the ultrasonic field. After the stability of the ultrasonic field is achieved, the sound pressure stabilizes at Pa. The designed multi-frequency transducer scheme creates a reverberant sound field with two different frequencies of ultrasonic waves in the enclosed space, enhancing and evenly distributing the cavitation effect, ensuring uniform acoustic intensity coverage throughout the entire container.
2.6. Verification of Software Functions for Ultrasonic–Thermal Synergistic Sterilization System
To validate the data acquisition and processing functions of the ultrasonic–thermal synergistic control software, as well as the accuracy of multi-frequency ultrasonic field distribution and pressure simulation, experiments were conducted under the operation of the ultrasonic–thermal synergistic control software to collect and process data on the propagation of multi-frequency ultrasonic waves in liquid egg medium. The software was set to 20 + 40 kHz, and the constant temperature heating temperature was set to 50 °C. The collected data included the current of ultrasonic transducers 1 and 2, the sweep frequency of the ultrasonic generator, the communication rate between all instruments and the upper computer, the real-time sterilization temperature of the liquid eggs, and the real-time sterilization time (countdown according to the designed time). The experimental data collection and processing document are shown in
Figure 9.
As shown in
Figure 9, it is evident that the ultrasonic frequency remains stable, with fluctuations within 0.3 kHz of the set frequency. The current in the ultrasonic generator is stable in the optimal working state of the transducer, and the liquid egg temperature is stable with fluctuations within 0.3 °C of the set temperature. Therefore, it can be concluded that the ultrasonic–thermal synergistic sterilization software played a role in controlling the start and stop of the ultrasonic and constant temperature devices and in monitoring the stability of the ultrasonic–thermal synergistic action during the experiment.
To validate whether the effect of the ultrasound–thermal synergistic device corresponds to the simulation results, an acoustic intensity test of liquid eggs under the operation of the ultrasound–thermal synergistic sterilization system was conducted. The experimental setup is shown in
Figure 10a. The model of the ultrasonic acoustic intensity detection device is YP0511F. The measured duration of acoustic intensity is 20 s, with a value recorded every 1 s. The simulated volumetric average acoustic intensity ranges from 1.05 to 1.5 W/cm
2, which is in good agreement with the actually measured field intensity. After 20 measurements, the average acoustic intensity can reach 1.24 W/cm
2, achieving a certain sterilization effect, as shown in
Figure 10b.
This section established a simulation model of an ultrasound–thermal synergistic sterilization system and validated the sterilization simulation model under the action of multi-frequency ultrasound using COMSOL 6.0 software. The results indicate that, after the pressure stabilizes within the multi-frequency ultrasound sterilization simulation model, ultrasound waves can cover the entire sterilization container, and the intensity of the average acoustic pressure within the model can meet the sterilization requirements. A synergistic ultrasound–thermal liquid egg sterilization test platform was constructed according to the design requirements, and a detailed introduction to the hardware functions and parameters was provided. An ultrasound–thermal synergistic sterilization software control system based on the Modbus communication protocol was established. The effectiveness of the ultrasound–thermal synergistic sterilization control software, and the data acquisition and processing functions, were verified through experiments, and the simulation was instrumentally validated to be in agreement with actual measured acoustic intensities, thereby confirming the accuracy of the sterilization simulation model.
2.7. Materials and Equipment for Ultrasonic–Thermal Synergistic Sterilization Experiment
Fresh eggs were purchased from the local fresh produce market; nutrient agar medium was obtained from Beijing ComWin Biotech (China) Co., Ltd.; chemicals such as sodium chloride and distilled water were procured from China National Pharmaceutical Group Corporation; and all reagents were of analytical grade (AR). Sterile operating table (SW-CJ-2D), Jinan Senya Experimental Instrument (China) Co., Ltd.; vertical pressure steam sterilizer (LX-B50L), Hefei Huatai Medical Equipment (China) Co., Ltd.; adjustable homogenizer (FSH-2A), Changzhou Tianrui Instrument (China) Co., Ltd.; small magnetic stirrer (CL19-1), Shanghai Sile Instrument (China) Co., Ltd.; electronic balance (LE204E/02), precision pH meter (S400-K), Mettler Toledo Technology (China) Co., Ltd.; constant temperature incubator (ADX-SHP-160), Wuhan Andexin Detection Equipment (China) Co., Ltd.
2.8. Experimental Design
2.8.1. Experimental Procedure
(1) Preparation of liquid whole egg: wash the eggs with warm water, sterilize with alcohol, crush under aseptic conditions, filter out the chalaza and egg yolk membrane, stir evenly with a magnetic stirrer at a speed of 1000 r/min, and store the liquid eggs in a sterile sealed bag in a refrigerator at 4 °C; (2) single-factor experiment: referring to the sterilization levels of Lee [
21], this experiment controls the effects of three factors: temperature (50, 55, 60 °C), time (7, 11, 15 min), and frequency (20, 20 + 28, 20 + 40 kHz) on the sterilization rate of liquid eggs; (3) response surface analysis experiment: based on the results of single-factor experiments, with temperature, time, and frequency as variables, a Box–Behnken design was used to conduct a 3-factor 3-level experiment to optimize the sterilization conditions. The optimization process of ultrasound–assisted thermal sterilization parameters is shown in
Figure 11.
2.8.2. Microbial Quantification
According to GB/T 4789.2-2016, colony counts are performed on liquid egg white samples before and after sterilization treatment. Colony counts are expressed in colony-forming units (CFU). The sterilization effect is indicated by the lethal rate, calculated using the following formula:
N0: Microbial count before sterilization treatment, CFU/mL; N: Microbial count after sterilization treatment, CFU/mL.
2.8.3. Determination of Sterilization Rate of Liquid Eggs
The determination of total bacterial count refers to GB/T 4789.2-2016 “Microbiological examination of food hygiene—Part 2: Examination of total number of colonies.” According to the national standard, the colony counts of the control group and experimental group are obtained, and their sterilization rates are calculated.
The bacterial lethality is calculated using the following formula:
In the formula, D represents the bacterial count of the sample without ultrasonic treatment, and E represents the bacterial count of the sample after ultrasonic treatment.
2.8.4. Determination of Physicochemical Properties of Liquid Eggs
- (1)
Determination of Foaming Capacity and Foaming Stability
Liquid eggs, with their excellent foaming properties, are widely used in the baking of products such as cakes and desserts. The study of the foaming capacity and foaming stability functional properties of liquid eggs is particularly important. After ultrasonic treatment, the homogeneous liquid sample (5 mL) is placed in a small test tube, and distilled water is added to make a 5% dilution solution with a volume of 100 mL. The liquid volume is recorded at this time. Under the action of a stirrer at 10,000 r/min, it is stirred for 1 min. The foaming volume and liquid volume are analyzed and recorded just after stirring stops and 30 min after stirring, and the foaming capacity (FC) and foaming stability (FS) are determined.
Foaming capacity (FC) is calculated using the following formula:
Foaming stability (FS) is determined using the following formula:
where: V
1 is the foam volume of the sample liquid at zero time after stirring (mL) and V
2 is the volume after standing for 30 min.
- (2)
Determination of pH Value
The sample is placed in a beaker, and the pH is measured at room temperature using a pH meter.
- (3)
Determination of Viscosity
Modified from the method in reference [
23]. Take 30 mL of the sample in a 50 mL beaker and measure the viscosity at room temperature using a rotational viscometer. Testing conditions: select rotor 1 and measure the viscosity of the liquid whole egg sample at 60 rpm.
5. Conclusions
This paper innovatively proposes a multi-frequency ultrasound–thermal synergistic sterilization method. Through COMSOL multi-physics simulation and sterilization experiments, the effects of multi-frequency combinations and thermal treatment parameters on sterilization performance and functional properties are explored. The optimal process parameters are determined as follows: ultrasound frequencies of 20 kHz + 40 kHz, treatment time of 11 min and 30 s, and heating temperature of 55 °C. In actual ultrasound–thermal synergistic sterilization experiments, a sterilization rate of 99.32% and a foaming property of 42.79% are achieved. The results indicate that, while ensuring sterilization performance, the method avoids significant damage to the functional properties of liquid eggs caused by the intense heat treatment of traditional pasteurization processes. The authors also hope that the ultrasonic sterilization system studied in this paper can be further technologically optimized and widely applied in other industries in the future. The conclusions are as follows:
(1) Utilizing COMSOL multi-physics field simulation, the acoustic pressure propagation attenuation of a single-frequency ultrasonic transducer in liquid egg medium was simulated. The results indicate that the horizontally covered distance of the 20 kHz ultrasonic transducer is approximately 200 mm, and the vertically propagated distance is about 100 mm. Based on this, a multi-frequency ultrasonic transducer arrangement scheme was designed, and a simulation of the multi-frequency ultrasonic field distribution was conducted. The results show that the designed multi-frequency sterilization scheme is reasonable. The simulated average sound pressure of ultrasonic waves ranges from 2.2 to 3.8 Pa. Through sound intensity detection experiments, it is verified that the required sound intensity effect for liquid egg sterilization can be achieved. A design for an ultrasonic–thermal synergistic liquid egg sterilization scheme and apparatus was formulated, and a control system based on the Modbus communication protocol was established. Through testing, the effectiveness of the control, data acquisition, and processing functions of the ultrasonic–thermal synergistic sterilization device were validated.
(2) Sterilization rate and foaming properties were used as evaluation indicators. Single-factor screening was conducted for ultrasonic frequency, action time, and heating temperature. Furthermore, a three-factor, three-level response surface experiment was carried out for ultrasonic frequency, action time, and heating temperature. Based on the variance analysis of the regression model, it was found that ultrasonic frequency has a significant correlation with the sterilization rate. The results indicate a strong correlation between ultrasonic frequency, action time, heating temperature, and sterilization performance. Multi-frequency ultrasound improves sterilization efficiency by approximately 15% compared to traditional single-source ultrasonic sterilization. The order of impact on sterilization rate was found to be: sterilization temperature > action time > ultrasonic frequency, demonstrating that the ultrasonic–thermal synergistic sterilization system has good sterilization effects on liquid eggs.
(3) Sterilization rate and foaming properties were optimized objectives using a genetic algorithm for multi-objective optimization. Combined with the response surface regression model, the following optimal process parameters were obtained: ultrasonic frequency of 20 kHz + 40 kHz, action time of 11 min and 30 s, and heating temperature of 55 °C. The predicted sterilization rate was 99.92%, and the foaming property was 45.80%. In actual ultrasonic–mild thermal synergistic sterilization experiments, the sterilization rate was 99.93%, there was an average decimal reduction of 3.17 log values, and the foaming property was 42.84%. Compared with national standards and traditional pasteurization, the ultrasonic–thermal synergistic sterilization control system ensures the quality of liquid eggs based on indicators such as foaming properties and viscosity while meeting national sterilization requirements.
The sterilization method and experiments proposed in this paper have not been applied to actual liquid egg production lines, and further work will involve the optimization and integrated application of ultrasonic–thermal synergistic sterilization equipment. In the future, this system could be promoted for use in fields such as food safety, maritime or medical industries for microbial contamination control, and drinking water sterilization.